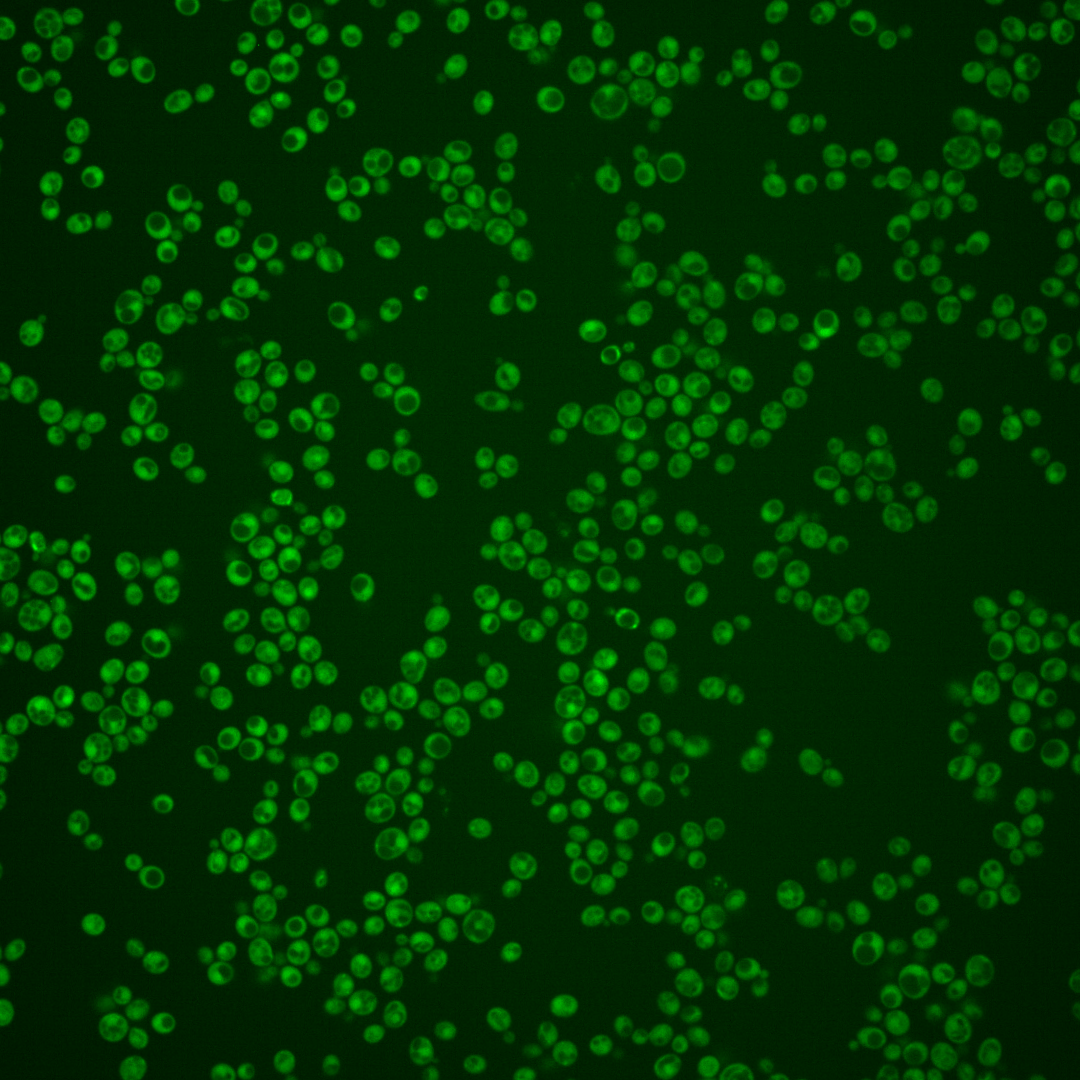
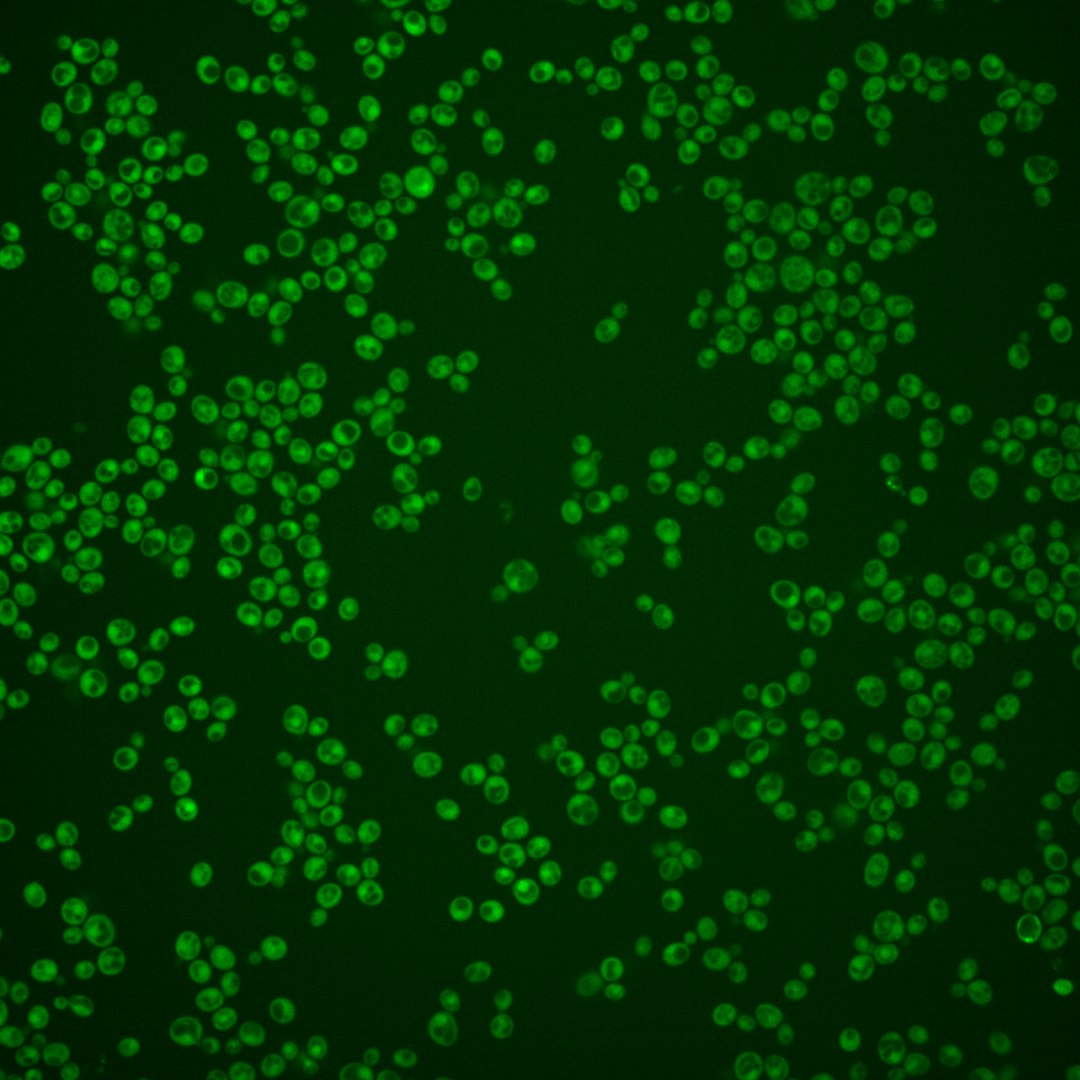
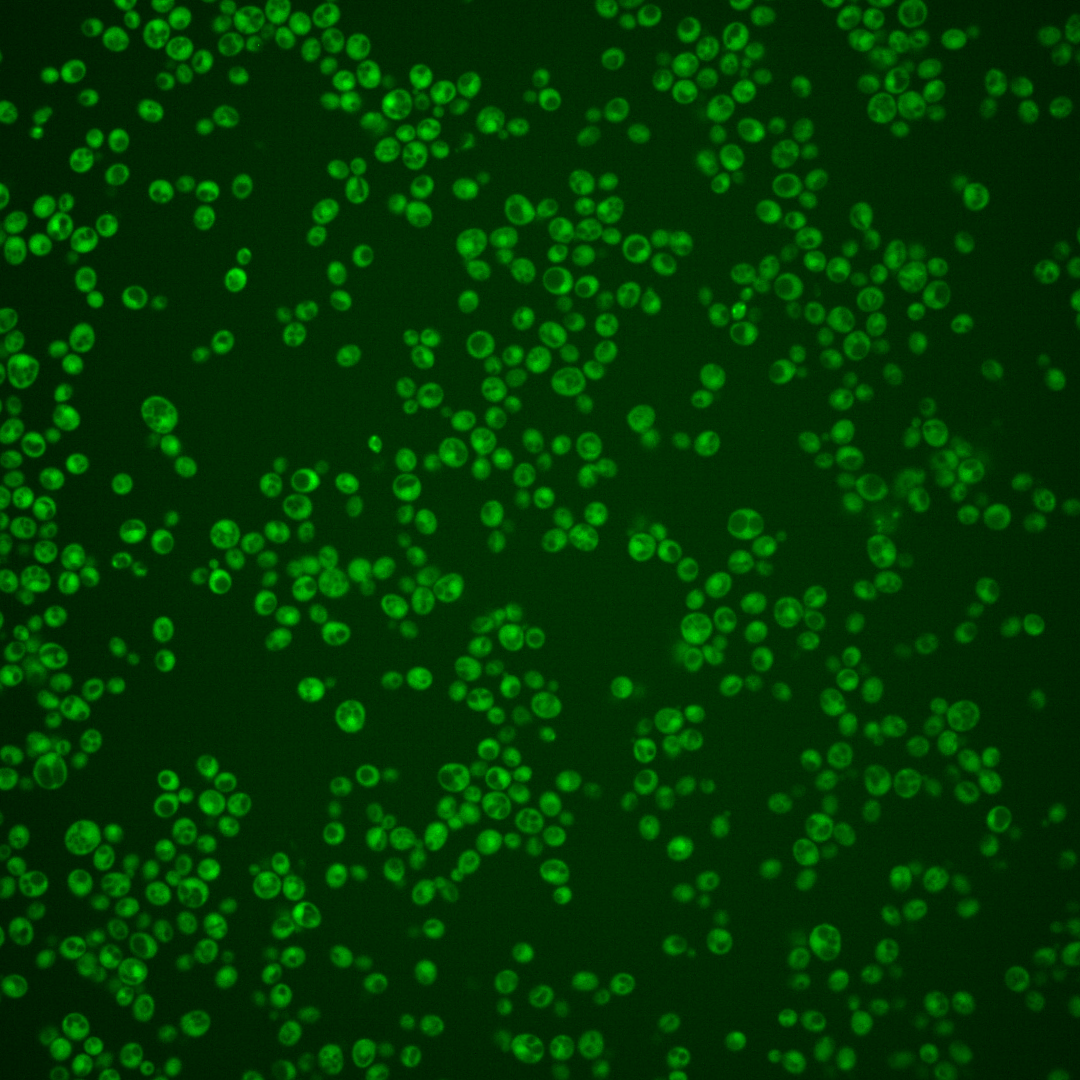
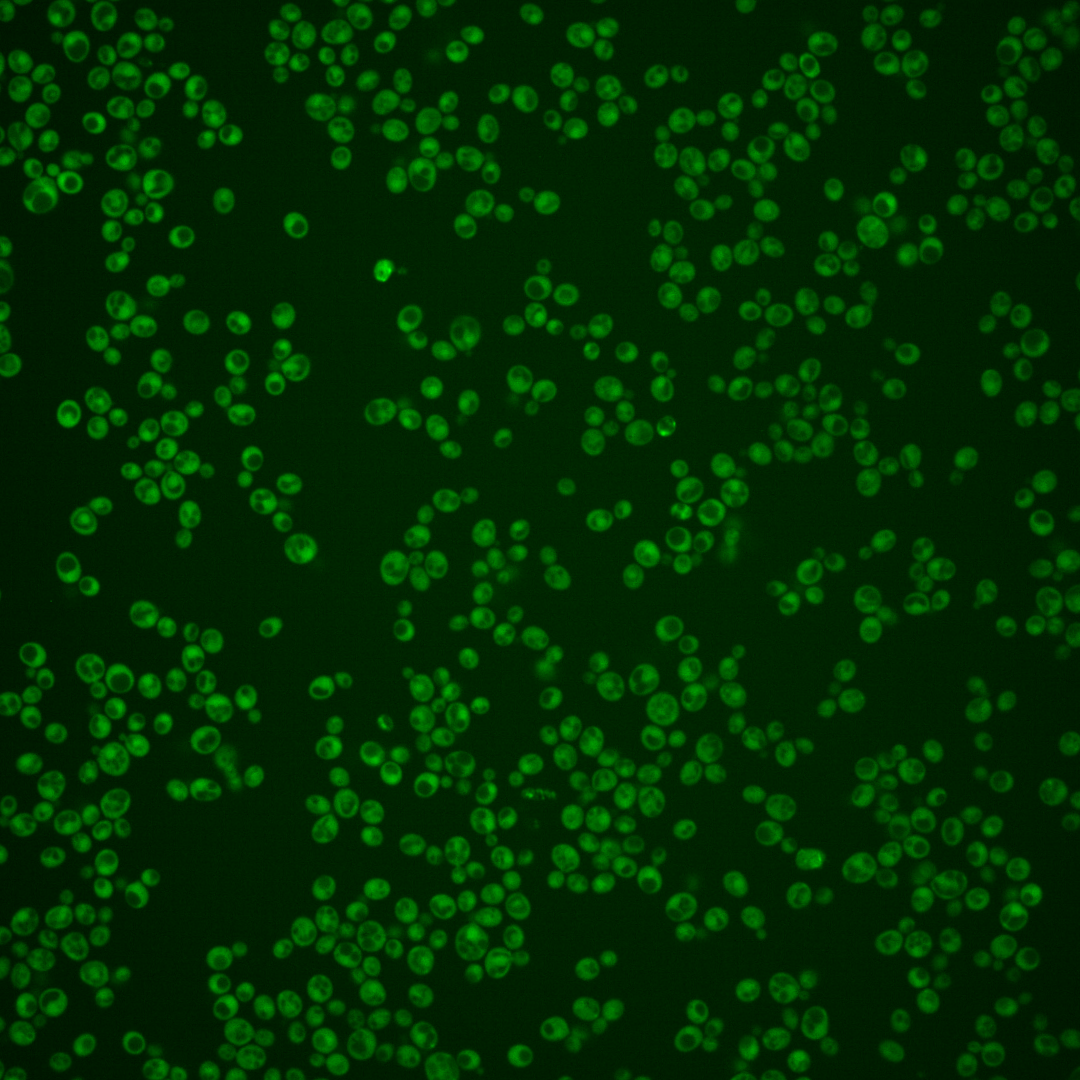

| Standard name | |
|---|---|
| Human Ortholog | |
| Description | Endosomal SNARE related to mammalian syntaxin 8 |
Micrographs




















































































Sub-cellular Localization
Yeast GFP Assignment
Protein Abundance
Localization Change
External localization resources
| ensLOC | DeepLoc | |||||||||||||||||||||||
|---|---|---|---|---|---|---|---|---|---|---|---|---|---|---|---|---|---|---|---|---|---|---|---|---|
| Localization | WT1 | WT2 | WT3 | RAP60 | RAP140 | RAP220 | RAP300 | RAP380 | RAP460 | RAP540 | RAP620 | RAP700 | HU80 | HU120 | HU160 | rpd3Δ_1 | rpd3Δ_2 | rpd3Δ_3 | WT1 | WT2 | WT3 | AF100 | AF140 | AF180 |
| Cortical Patches | 0 | 0 | 0 | 0 | 0 | 0 | 0 | – | 1 | 1 | 0 | 0 | 0 | 0 | 0 | 0 | 0 | 0 | 0 | 0 | 0 | 1 | 1 | 0 |
| Bud | 0 | 0 | 0 | 0 | 0 | 3 | 5 | – | 9 | 9 | 14 | 6 | 0 | 1 | 0 | 0 | 0 | 1 | 0 | 0 | 1 | 2 | 4 | 2 |
| Bud Neck | 0 | 0 | 0 | 0 | 0 | 0 | 0 | – | 0 | 1 | 1 | 0 | 0 | 0 | 0 | 0 | 0 | 0 | 0 | 0 | 0 | 0 | 0 | 0 |
| Bud Site | 0 | 0 | 0 | 0 | 0 | 0 | 0 | – | 0 | 0 | 0 | 1 | 0 | 0 | 0 | 0 | 0 | 0 | – | – | – | – | – | – |
| Cell Periphery | 1 | 0 | 0 | 1 | 2 | 1 | 8 | – | 5 | 7 | 6 | 11 | 1 | 0 | 5 | 6 | 6 | 9 | 0 | 0 | 0 | 0 | 0 | 0 |
| Cytoplasm | 76 | 69 | 48 | 242 | 361 | 255 | 505 | – | 311 | 354 | 272 | 321 | 211 | 561 | 601 | 224 | 195 | 243 | 80 | 81 | 78 | 269 | 396 | 437 |
| Endoplasmic Reticulum | 0 | 1 | 0 | 0 | 0 | 1 | 0 | – | 1 | 0 | 0 | 0 | 1 | 1 | 2 | 7 | 9 | 6 | 0 | 0 | 0 | 2 | 2 | 2 |
| Endosome | 0 | 0 | 0 | 0 | 0 | 0 | 2 | – | 0 | 0 | 0 | 0 | 0 | 1 | 0 | 0 | 0 | 0 | 1 | 1 | 0 | 1 | 2 | 2 |
| Golgi | 0 | 0 | 0 | 0 | 0 | 0 | 0 | – | 0 | 0 | 0 | 0 | 0 | 1 | 1 | 1 | 0 | 0 | 0 | 1 | 0 | 1 | 3 | 2 |
| Mitochondria | 3 | 4 | 0 | 2 | 4 | 39 | 46 | – | 140 | 121 | 145 | 172 | 0 | 0 | 1 | 5 | 1 | 1 | 0 | 1 | 0 | 0 | 2 | 0 |
| Nucleus | 0 | 0 | 0 | 1 | 2 | 5 | 11 | – | 18 | 18 | 21 | 17 | 0 | 1 | 0 | 7 | 4 | 2 | 1 | 0 | 0 | 0 | 3 | 0 |
| Nuclear Periphery | 1 | 2 | 0 | 0 | 0 | 0 | 2 | – | 4 | 1 | 1 | 2 | 0 | 0 | 0 | 0 | 0 | 0 | 0 | 0 | 1 | 0 | 0 | 0 |
| Nucleolus | 0 | 0 | 0 | 0 | 0 | 0 | 0 | – | 1 | 1 | 1 | 0 | 0 | 0 | 1 | 0 | 0 | 0 | 0 | 0 | 0 | 0 | 0 | 0 |
| Peroxisomes | 0 | 0 | 0 | 0 | 0 | 0 | 0 | – | 0 | 0 | 0 | 0 | 0 | 0 | 0 | 0 | 0 | 0 | 0 | 0 | 0 | 0 | 0 | 0 |
| SpindlePole | 0 | 0 | 0 | 0 | 0 | 0 | 0 | – | 0 | 0 | 0 | 0 | 0 | 0 | 0 | 0 | 0 | 0 | 0 | 0 | 0 | 1 | 2 | 1 |
| Vac/Vac Membrane | 2 | 1 | 0 | 9 | 14 | 12 | 109 | – | 62 | 48 | 30 | 35 | 0 | 4 | 15 | 12 | 9 | 14 | 2 | 3 | 0 | 6 | 5 | 3 |
| Unique Cell Count | 81 | 74 | 48 | 248 | 373 | 289 | 611 | 445 | 488 | 421 | 485 | 211 | 565 | 610 | 239 | 202 | 254 | 88 | 91 | 84 | 292 | 431 | 459 | |
| Labelled Cell Count | 83 | 77 | 48 | 255 | 383 | 316 | 688 | 552 | 561 | 491 | 565 | 213 | 570 | 626 | 262 | 224 | 276 | 88 | 91 | 84 | 292 | 431 | 459 | |
Yeast GFP Assignment
Protein Abundance
| Screen | WT1 | WT2 | WT3 | RAP60 | RAP140 | RAP220 | RAP300 | RAP380 | RAP460 | RAP540 | RAP620 | RAP700 | HU80 | HU120 | HU160 | rpd3Δ_1 | rpd3Δ_2 | rpd3Δ_3 | AF100 | AF140 | AF180 |
|---|---|---|---|---|---|---|---|---|---|---|---|---|---|---|---|---|---|---|---|---|---|
| Mean Cell GFP Intensity (1e-4) | 5.7 | 5.6 | 6.4 | 6.2 | 7.0 | 5.1 | 6.1 | – | 5.3 | 5.4 | 5.2 | 5.4 | 7.0 | 7.2 | 7.4 | 8.0 | 8.4 | 8.5 | 6.1 | 6.4 | 6.5 |
| Std Deviation (1e-4) | 0.8 | 0.7 | 2.0 | 1.3 | 1.2 | 1.3 | 1.1 | – | 1.2 | 1.0 | 0.9 | 1.0 | 1.0 | 1.2 | 1.3 | 1.1 | 1.1 | 1.2 | 1.1 | 1.4 | 1.4 |
| Intensity Change (Log2) | – | – | – | -0.04 | 0.12 | -0.32 | -0.06 | – | -0.26 | -0.24 | -0.3 | -0.23 | 0.14 | 0.17 | 0.21 | 0.32 | 0.39 | 0.41 | -0.06 | -0.01 | 0.03 |
Localization Change
| Localization | RAP60 | RAP140 | RAP220 | RAP300 | RAP380 | RAP460 | RAP540 | RAP620 | RAP700 | HU80 | HU120 | HU160 | rpd3Δ_1 | rpd3Δ_2 | rpd3Δ_3 |
|---|---|---|---|---|---|---|---|---|---|---|---|---|---|---|---|
| Cortical Patches | 0 | 0 | 0 | 0 | – | 0 | 0 | 0 | 0 | 0 | 0 | 0 | 0 | 0 | 0 |
| Bud | 0 | 0 | 0 | 0 | – | 0 | 0 | 0 | 0 | 0 | 0 | 0 | 0 | 0 | 0 |
| Bud Neck | 0 | 0 | 0 | 0 | – | 0 | 0 | 0 | 0 | 0 | 0 | 0 | 0 | 0 | 0 |
| Bud Site | 0 | 0 | 0 | 0 | – | 0 | 0 | 0 | 0 | 0 | 0 | 0 | 0 | 0 | 0 |
| Cell Periphery | 0 | 0 | 0 | 0 | – | 0 | 0 | 0 | 0 | 0 | 0 | 0 | 0 | 0 | 0 |
| Cytoplasm | -1.1 | -1.3 | -2.5 | -3.2 | – | -4.5 | -4.2 | -5.0 | -4.8 | 0 | -0.6 | -0.8 | -1.8 | -1.3 | -1.5 |
| Endoplasmic Reticulum | 0 | 0 | 0 | 0 | – | 0 | 0 | 0 | 0 | 0 | 0 | 0 | 0 | 0 | 0 |
| Endosome | 0 | 0 | 0 | 0 | – | 0 | 0 | 0 | 0 | 0 | 0 | 0 | 0 | 0 | 0 |
| Golgi | 0 | 0 | 0 | 0 | – | 0 | 0 | 0 | 0 | 0 | 0 | 0 | 0 | 0 | 0 |
| Mitochondria | 0 | 0 | 2.7 | 0 | – | 4.6 | 3.9 | 4.9 | 5.0 | 0 | 0 | 0 | 0 | 0 | 0 |
| Nucleus | 0 | 0 | 0 | 0 | – | 0 | 0 | 0 | 0 | 0 | 0 | 0 | 0 | 0 | 0 |
| Nuclear Periphery | 0 | 0 | 0 | 0 | – | 0 | 0 | 0 | 0 | 0 | 0 | 0 | 0 | 0 | 0 |
| Nucleolus | 0 | 0 | 0 | 0 | – | 0 | 0 | 0 | 0 | 0 | 0 | 0 | 0 | 0 | 0 |
| Peroxisomes | 0 | 0 | 0 | 0 | – | 0 | 0 | 0 | 0 | 0 | 0 | 0 | 0 | 0 | 0 |
| SpindlePole | 0 | 0 | 0 | 0 | – | 0 | 0 | 0 | 0 | 0 | 0 | 0 | 0 | 0 | 0 |
| Vacuole | 0 | 0 | 0 | 3.2 | – | 2.8 | 0 | 0 | 0 | 0 | 0 | 0 | 0 | 0 | 0 |
External localization resources
Images






























Protein Concentration and Protein Localization Data
| R1 | R2 | R3 | ||||||||||||||||
|---|---|---|---|---|---|---|---|---|---|---|---|---|---|---|---|---|---|---|
| G1 Pre-START | G1 Post-START | S/G2 | Metaphase | Anaphase | Telophase | G1 Pre-START | G1 Post-START | S/G2 | Metaphase | Anaphase | Telophase | G1 Pre-START | G1 Post-START | S/G2 | Metaphase | Anaphase | Telophase | |
| Concentration | 0.4195 | 0.0726 | 0.1967 | 0.0093 | -0.1692 | 0.507 | 0.9539 | 1.8383 | 1.3956 | 1.1043 | 1.1524 | 1.5681 | 2.5713 | 3.7381 | 2.9095 | 3.2805 | 2.8999 | 3.1873 |
| Actin | 0.0268 | 0.0026 | 0.0191 | 0.0105 | 0.0169 | 0.005 | 0.0369 | 0.0008 | 0.0051 | 0.085 | 0.0373 | 0.0058 | 0.0133 | 0.0001 | 0.0138 | 0.0034 | 0.0249 | 0.0069 |
| Bud | 0.001 | 0.0012 | 0.0025 | 0.0002 | 0.0003 | 0.0027 | 0.0005 | 0.0002 | 0.0003 | 0.0206 | 0.002 | 0.0001 | 0.0001 | 0 | 0.0003 | 0.0003 | 0.0001 | 0.0002 |
| Bud Neck | 0.0027 | 0.0005 | 0.0004 | 0.0444 | 0.0007 | 0.0014 | 0.0008 | 0.0002 | 0.0056 | 0.0015 | 0.0015 | 0.0006 | 0.0003 | 0.0001 | 0.0007 | 0.0007 | 0.0041 | 0.0024 |
| Bud Periphery | 0.0021 | 0.001 | 0.0032 | 0.0003 | 0.0003 | 0.0012 | 0.0007 | 0.0001 | 0.0003 | 0.0296 | 0.0034 | 0.0001 | 0.0001 | 0 | 0.0003 | 0.0002 | 0.0001 | 0.0002 |
| Bud Site | 0.003 | 0.0076 | 0.0053 | 0.001 | 0.001 | 0.002 | 0.0014 | 0.0023 | 0.0019 | 0.0617 | 0.0029 | 0.0001 | 0.0004 | 0.0003 | 0.0038 | 0.0004 | 0.0005 | 0.0002 |
| Cell Periphery | 0.0005 | 0.0002 | 0.0006 | 0.0002 | 0.0001 | 0.0006 | 0.0001 | 0.0001 | 0.0003 | 0.0007 | 0.0003 | 0.0001 | 0.0001 | 0.0001 | 0.0003 | 0 | 0.0002 | 0 |
| Cytoplasm | 0.4773 | 0.6836 | 0.6179 | 0.4959 | 0.6107 | 0.7015 | 0.6039 | 0.7754 | 0.7739 | 0.4622 | 0.6296 | 0.813 | 0.6106 | 0.7349 | 0.6334 | 0.702 | 0.6646 | 0.71 |
| Cytoplasmic Foci | 0.0341 | 0.0234 | 0.0195 | 0.0449 | 0.0483 | 0.0242 | 0.0141 | 0.0037 | 0.0071 | 0.0086 | 0.0256 | 0.0099 | 0.0076 | 0.0018 | 0.0086 | 0.0146 | 0.0125 | 0.0106 |
| Eisosomes | 0.0003 | 0.0001 | 0.0014 | 0.0002 | 0.0001 | 0 | 0.0003 | 0 | 0.0003 | 0.0022 | 0.001 | 0 | 0.0002 | 0 | 0.0001 | 0 | 0.0001 | 0 |
| Endoplasmic Reticulum | 0.0577 | 0.004 | 0.0291 | 0.0566 | 0.0385 | 0.0442 | 0.0033 | 0.003 | 0.0028 | 0.0029 | 0.0034 | 0.0051 | 0.0031 | 0.0013 | 0.0025 | 0.0023 | 0.0013 | 0.0016 |
| Endosome | 0.0314 | 0.0137 | 0.0086 | 0.0144 | 0.0207 | 0.0087 | 0.0099 | 0.0013 | 0.0047 | 0.0103 | 0.0331 | 0.0053 | 0.0052 | 0.0005 | 0.0042 | 0.0418 | 0.0065 | 0.0025 |
| Golgi | 0.0106 | 0.0007 | 0.0025 | 0.0012 | 0.0032 | 0.0027 | 0.0045 | 0.0001 | 0.0004 | 0.0065 | 0.0143 | 0.0014 | 0.0025 | 0 | 0.001 | 0.0071 | 0.0022 | 0.0016 |
| Lipid Particles | 0.0098 | 0.0012 | 0.0055 | 0.0018 | 0.0043 | 0.008 | 0.0067 | 0.0001 | 0.0002 | 0.0055 | 0.0355 | 0.0019 | 0.0055 | 0 | 0.0007 | 0.01 | 0.0296 | 0.0015 |
| Mitochondria | 0.0095 | 0.0005 | 0.0045 | 0.0007 | 0.0016 | 0.0017 | 0.003 | 0.0002 | 0.0005 | 0.0244 | 0.0305 | 0.0002 | 0.0017 | 0.0001 | 0.0006 | 0.0013 | 0.0009 | 0.003 |
| None | 0.2998 | 0.2425 | 0.2445 | 0.3123 | 0.2343 | 0.1661 | 0.3013 | 0.2058 | 0.1893 | 0.2486 | 0.109 | 0.138 | 0.3264 | 0.2572 | 0.3145 | 0.2037 | 0.2346 | 0.2469 |
| Nuclear Periphery | 0.0065 | 0.0028 | 0.0091 | 0.0056 | 0.003 | 0.0028 | 0.0021 | 0.0021 | 0.0012 | 0.0038 | 0.0091 | 0.0066 | 0.0047 | 0.0005 | 0.0011 | 0.0019 | 0.0012 | 0.0006 |
| Nucleolus | 0.0026 | 0.0003 | 0.0006 | 0.0002 | 0.0004 | 0.0007 | 0.0002 | 0.0001 | 0.0001 | 0.0011 | 0.0012 | 0.0001 | 0.0004 | 0 | 0.0004 | 0.0001 | 0.0019 | 0 |
| Nucleus | 0.0066 | 0.0072 | 0.0096 | 0.0029 | 0.0031 | 0.0099 | 0.0023 | 0.0028 | 0.0034 | 0.0072 | 0.0076 | 0.0071 | 0.0022 | 0.0023 | 0.004 | 0.0025 | 0.0022 | 0.0041 |
| Peroxisomes | 0.0066 | 0.0005 | 0.0084 | 0.0014 | 0.0017 | 0.0015 | 0.0045 | 0.0001 | 0.0003 | 0.0113 | 0.0197 | 0.0003 | 0.0095 | 0 | 0.0042 | 0.0044 | 0.0072 | 0.0047 |
| Punctate Nuclear | 0.0067 | 0.0034 | 0.0043 | 0.0029 | 0.0087 | 0.0127 | 0.0022 | 0.0007 | 0.0007 | 0.0018 | 0.0255 | 0.0035 | 0.0048 | 0.0002 | 0.0015 | 0.0022 | 0.0007 | 0.0026 |
| Vacuole | 0.0032 | 0.0026 | 0.0025 | 0.0016 | 0.0017 | 0.0019 | 0.0009 | 0.0007 | 0.0015 | 0.0031 | 0.0044 | 0.0006 | 0.0008 | 0.0004 | 0.0037 | 0.0007 | 0.003 | 0.0003 |
| Vacuole Periphery | 0.0012 | 0.0004 | 0.0007 | 0.0007 | 0.0004 | 0.0003 | 0.0003 | 0.0001 | 0.0003 | 0.0013 | 0.0031 | 0.0002 | 0.0003 | 0 | 0.0002 | 0.0005 | 0.0016 | 0.0001 |
Sequencing Data
| R1 | R2 | |||||||||
|---|---|---|---|---|---|---|---|---|---|---|
| G1 Post-START | S/G2 | Metaphase | Anaphase | Telophase | G1 Post-START | S/G2 | Metaphase | Anaphase | Telophase | |
| Gene Expression | 25.1427 | 12.8434 | 31.4503 | 34.1409 | 25.1475 | 27.2827 | 30.5171 | 33.3057 | 37.2869 | 30.6298 |
| Translational Efficiency | 0.7931 | 1.6176 | 0.6193 | 0.6021 | 0.6665 | 0.8408 | 0.6806 | 0.584 | 0.536 | 0.6566 |
Hit Data
| Dataset | Hit |
|---|---|
| Protein Concentration | ✘ |
| Protein Localization | ✘ |
| Gene Expression | ✘ |
| Translational Efficiency | ✘ |
Endocytosis
| Temp | Actin Patch (Sac6-tdTomato) | Cortical Patch (Sla1-GFP) | Late Endosome (Snf7-GFP) | Vacuole (Vph1-GFP) |
|---|---|---|---|---|
| 37℃ | ||||
| RT |
Cell Cycle Omics
CYCLoPs (Syn8-GFP)
| Gene / Allele | Actin Patch (Sac6-tdTomato) | Cortical Patch (Sla1-GFP) | Late Endosome (Snf7-GFP) | Vacuole (Sac6-tdTomato) |
|---|
| Gene | Images |
|---|
| Gene | Images |
|---|
Images are not yet available
Images are not yet available